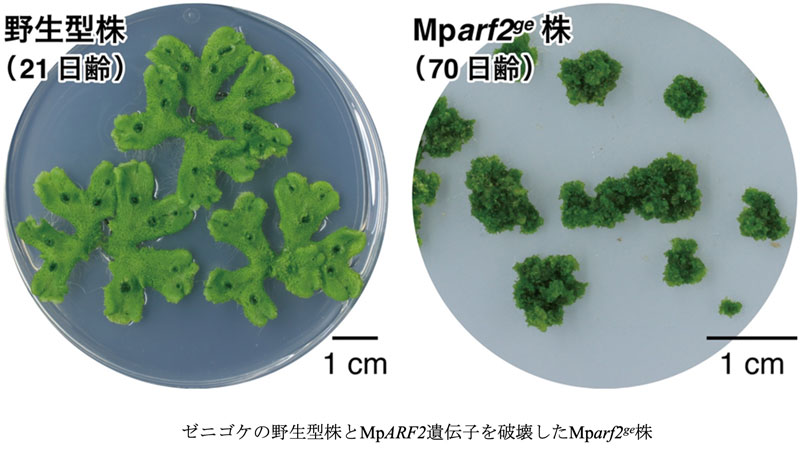
2512_main_Kohchi.jpg

河内孝之 生命科学研究科教授、灰庭瑛実 同修士課程学生(研究当時)、木南武 同修士課程学生(研究当時)、西浜竜一 東京理科大学教授(元生命科学研究科准教授)、今井雄星 同修士課程学生(研究当時)、鈴木秀政 東北大学助教(元生命科学研究科博士課程学生)、湯本絵美 帝京大学技術職員、朝比奈雅志 同教授らは、オーストラリア・モナシュ大学(Monash University)、英国ケンブリッジ大学(University of Cambridge)と共同で、植物の幹細胞は分化を促進するホルモンを作るものの、自身はその影響を受けずに周辺で器官形成を促す成長点形成のしくみがあり、それが植物の永続的な成長の基盤となっていることを明らかにしました。本成果は植物の巧みな発生戦略と陸上植物の繁栄を導いた進化の一端を明らかにする発見であり、植物のサイズや形を自在に制御する技術の開発につながると期待されます。
植物は成長点に存在する幹細胞が未分化性を保ちながら分裂を続けることで、一生にわたり新しい器官をつくり続けます。本研究では、こうした無限成長のしくみをコケ植物のゼニゴケを用いて明らかにしました。研究チームは、植物ホルモン「オーキシン」の作用を抑える転写因子MpARF2に着目し、その機能を解析しました。その結果、MpARF2 は幹細胞領域で高く発現してオーキシン応答を抑える一方、オーキシン生合成酵素を活性化し、幹細胞自身がオーキシンを生産するしくみを支えていることが分かりました。生産されたオーキシンは周辺領域へ運ばれ、器官形成を促すシグナルとして働きます。つまり幹細胞領域は、周囲の細胞の分化を制御しつつ、自らはその影響を受けない司令塔(オーガナイザー)として機能しており、MpARF2はその中核的な因子であることが明らかになりました。本成果は、植物の永続的な成長を支える基本原理の解明に大きく貢献するものです。
本研究成果は、2025年12月5日に、国際科学雑誌「Current Biology」にオンライン掲載されました。
研究者のコメント
「モデル生物として理想的な特徴であるゼニゴケの遺伝子重複の少なさを活かして、植物の細胞分化を促進するホルモンであるオーキシンを産生する幹細胞が未分化でいることができる謎、ひいては植物が無限に成長する仕組みの一端を解明することができました。外国人共同研究者として研究開始の直後にコロナ禍が始まったため離日せざるを得なかった筆頭著者、当時の大学院生、准教授とともに継続して進めた共同研究が実を結んだことも嬉しいことです。」(河内孝之)
【DOI】
https://doi.org/10.1016/j.cub.2025.11.015
【KURENAIアクセスURL】
http://hdl.handle.net/2433/298974
【書誌情報】
Eduardo Flores-Sandoval, Hidemasa Suzuki, Jessica A. Lazner, Liam N. Briginshaw, Tom J. Fisher, Facundo Romani, Jonathan Levins, Emi Hainiwa, Takeshi Kinami, Yusei Imai, Emi Yumoto, Masashi Asahina, Takayuki Kohchi, Ryuichi Nishihama, John L. Bowman (2025). The B-class auxin response factor MpARF2 is essential for meristem organization in free-living plant gametophytes. Current Biology, 36, 2, 261-277.





